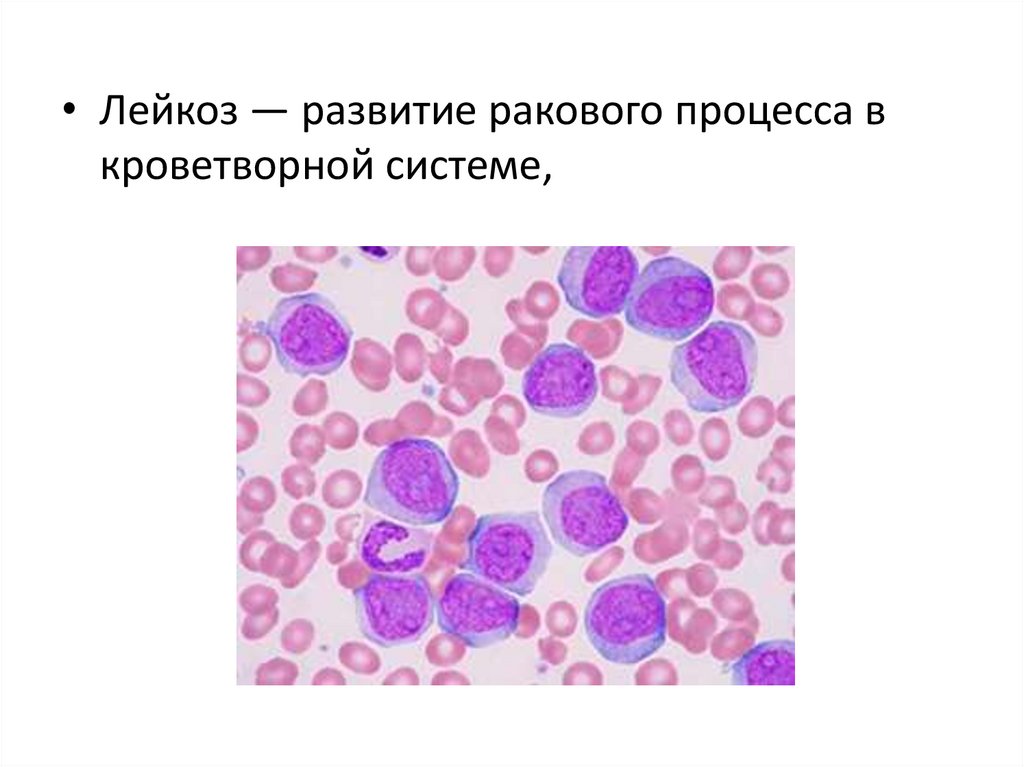

Similar presentations:
Опухоли. Доброкачественные и злокачественные опухоли. Рак. Виды рака
1.
Опухоли. Доброкачественные излокачественные опухоли.
Рак. Виды рака.
2.
Понятие• Неоплазия – «новый рост», т.е.
новообразование.
• Опухоль - патологический процесс, в
основе которого лежит безграничное и
нерегулируемое размножение клеток, не
достигающих созревания.
3.
Лейомиома матки.Доброкачественное
новообразование
4.
Злокачественное новообразованиелегкого.
5.
Аденокарцинома тела желудка.Злокачественный процесс.
6.
• Опухолевый атипизм - качественное и/иликоличественное отличие свойств опухоли от
нормальной (аутологичной) ткани (из
которой произошло новообразование), а
также от других патологически измененных
тканей (например, гипертрофированных,
атрофированных, рубцовой)
7.
Признаки атипизма:• Атипизм роста (атипизм
деления(патологические митозы), созревания,
инвазивный рост).
• Метаболический атипизм. Атипизм обмена
веществ (метаболический, или биохимический
атипизм) заключается в существенном
изменении всех видов обмена: нуклеиновых
кислот, белков, углеводов, липидов, ионов,
жидкости, витаминов
8.
Тканевой атипизм• Нарушение
взаимопол
ожения
клеток, но
состояние
клеток не
изменено.
9.
Клеточный атипизмПолиморфные ядра,
гипер или
гипохромные ядра,
патологические
митозы
10.
Атипизм функций:• Гипофункция. Опухолевые клетки и
новообразование в целом характеризуются
пониженным функционированием.
• Гиперфункция. Нередко наблюдают признаки
гиперфункции (гормональноактивные
новообразования желёз внутренней секреции
в избытке синтезируют гормоны).
• Дисфункция. В некоторых опухолях
выявляются признаки, не свойственные для
нормальных аутологичных тканей
11.
• Опухолевый рост - наиболеераспространенный и древнейший
патологический процесс. Нет живой
системы, в которой не могла бы развиться
опухоль.
12.
• Если опухольрастёт в просвет
полого органа это экзофидный
рост.
13.
14.
15.
• Если опухольрастёт в стенку
органа это эндофидный
рост.
16.
17.
• Экспансивный рост• Инвазивный рост
18.
Факторы риска• Риск развития злокачественных опухолей от
факторов окружающей среды составляет
65%, от генетических факторов — от 26 до
42%.
• Возраст. Частота злокачественных опухолей
обычно увеличивается с возрастом. Это
можно объяснить: - накоплением с
возрастом соматических мутаций, снижением иммунной резистентности,
ассоциированной с возрастом.
19.
Приобретенные предопухолевыесостояния
• Регенерация, метаплазия, гиперплазия, а
также дисплазия служат плодородной
почвой для развития злокачественной
опухоли.
20.
Этиология• Опухолевая
трансформация процесс превращения
нормальных клеток в
опухолевые
вследствие
трансформации
нормальной
генетической
программы в
программу
формирования
опухолевого
атипизма.
21.
Причины• Химические канцерогены вызывают 75% всех
злокачественных опухолей (продукты сгорания
табака, некоторые компоненты пищи и
промышленные соединения).
• Физические канцерогены (ионизирующее
излучение, рентгеновские и ультрафиолетовые
лучи).
• Онкогенные вирусы (ДНК-содержащие
онковирусы - некоторые аденовирусы,
герпесвирусы; РНК-содержащие вирусы,
относящиеся к ретровирусам).
22.
Патогенез• Канцерогенез - механизм развития опухолевого
роста, многоступенчатый процесс, развивающийся
вследствие накопления множественных мутаций.
• Выделяют две фазы развития злокачественных
опухолей — инициация и промоция
• фаза инициации - результат воздействия на клетку
достаточной дозы канцерогенного агента; клетка
повреждается (мутации ДНК) и становится
потенциально способной начать опухолевый рост
• промоторы воздействуют на инициированные
клетки, но при этом сами не обладают
онкогенностью.
23.
24.
• Метастазы — это вторичные очагипоражения, которые возникают в
результате распространения клеток
первичного злокачественного
новообразования по организму. Какое-то
время они никак не проявляют себя.
25.
Пути метастазирования• Лимфогенные метастазы. Клетки опухоли
распространяются по организму через
лимфатическую систему. С током лимфы
они вначале попадают в лимфоузел,
задерживаются в нем. Пораженный
опухолью лимфоузел меняет форму,
васкуляризацию, появляются
дополнительные включения
26.
• Гематогенные метастазы. Клетки опухолираспространяются по сосудам.
Гематогенное метастазирование обычно
происходит по венам. По артериям клетки
опухоли мигрируют крайне редко, что
связано с целым рядом особенностей
данного типа сосудов. А вот венозный путь
используется постоянно
27.
28.
29.
30.
31.
Рак.• Рак – это общее название для обширной
группы онкологических заболеваний, при
которых клетки тела начинают
бесконтрольный рост и деление.
• Без лечения эти заболевания становятся
смертельными.
32.
Виды рака• Карцинома – рак в эпителии
33.
34.
• Меланома — рак кожи. Развивается измеланоцитов
35.
• Саркома — рак в соединительной тканиСаркома
Юинга
36.
• Лейкоз — развитие ракового процесса вкроветворной системе,
37.
• Лимфома Ходжкина(лимфогранулематоз)— рак в
лимфатической системе.
Клетки
Березовского Штернберга
38.
• Глиома — рак головного мозга и другойнервной ткани.

medicine
medicine








